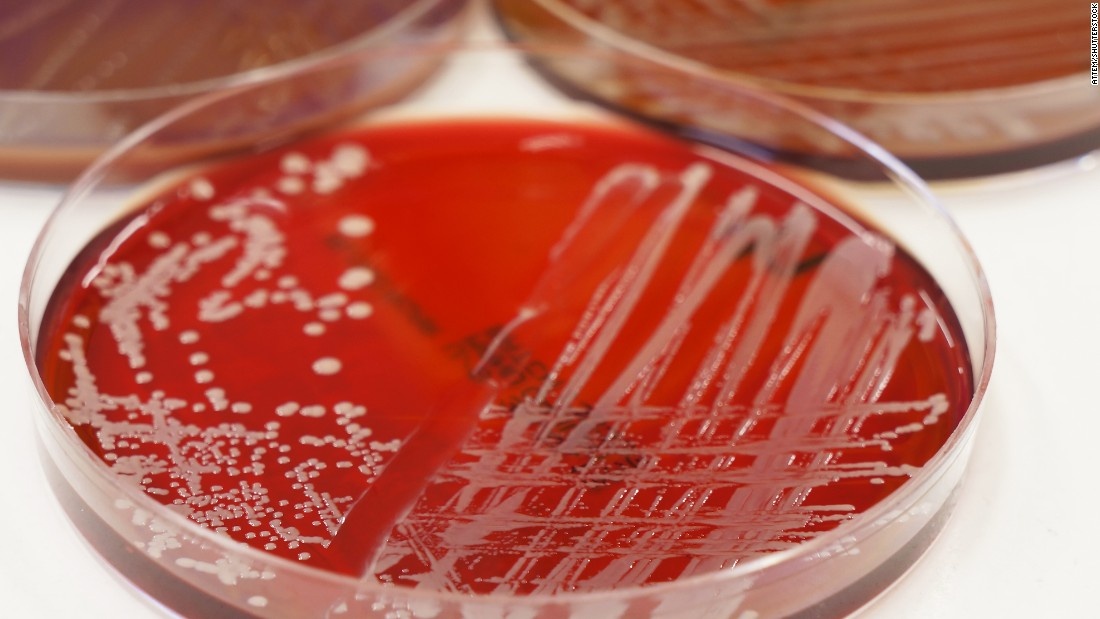
Sai lam y khoa pho bien trong cac benh vien anh 7

|
|
|
1. Thức dậy trong khi phẫu thuật: Theo CNN, không gây mê đủ lượng trong quá trình phẫu thuật có thể khiến não bộ của bệnh nhân tỉnh táo và nhận thức trong khi cơ bắp ở trạng thái đông lạnh. Điều này được gọi là "nhận thức trong lúc gây mê", xảy ra ở 1/1.000 bệnh nhân. Khi chuẩn bị phẫu thuật, bệnh nhân có thể yêu cầu bác sĩ gây mê cục bộ (gây mê không có cảm giác nhưng vẫn có ý thức) nếu được phép.
|
|
|
|
2. Nhầm trẻ sơ sinh: Trẻ sơ sinh thường khá giống nhau, không dễ dàng để phân biệt, đặc biệt là ở trong bệnh viện khi bạn mới chỉ nhìn con mình 1-2 lần. Vì vậy, khi được gặp con lần đầu, hãy hỏi y tá về đặc điểm nhận dạng riêng biệt của bé.
|
|
|
|
3. Điều trị nhầm bệnh nhân: Rất nhiều người trùng tên với nhau, đôi khi, bệnh viện có thể điều trị nhầm lẫn các bệnh nhân. Trước khi làm các thủ tục trong bệnh viện, bạn nên yêu cầu các nhân viên y tế kiểm tra kỹ toàn bộ họ tên, ngày sinh và mã vạch trên cổ tay của mình.
|
|
|
|
4. Mổ sai bộ phận: Ở Mỹ, mỗi ngày có tới 7 bệnh nhân bị phẫu thuật nhầm bộ phận. Do vậy, điều này là hoàn toàn có thể xảy ra với bất kỳ ai. Điều bệnh nhân cần làm trước khi phẫu thuật là khẳng định lại với y tá, bác sĩ phẫu thuật về bộ phận mình cần mổ, đặc biệt là bên trái/phải chính xác.
|
|
|
|
5. Quên dụng cụ y tế trong người bệnh nhân: Y tá có nhiệm vụ theo dõi, kiểm soát bao nhiêu dụng cụ dùng để phẫu thuật và phải chắc chắn có đúng bấy nhiêu dụng cụ sau khi thực hiện xong. Để quên dụng cụ phẫu thuật trong người bệnh nhân xảy ra ở 2/10.000 ca phẫu thuật. Nếu bạn bị đau đột ngột, sốt hoặc sưng sau khi phẫu thuật, hãy yêu cầu bác sĩ kiểm tra kỹ càng để chắc chắn không có dụng cụ nào trong người. |
|
|
|
6. Chẩn đoán nhầm: Trong số 10 chẩn đoán, bạn lại nhận được 1 chẩn đoán sai từ bác sĩ. Nếu cảm thấy không đúng với trường hợp bệnh của mình, hãy hỏi ý kiến của bác sĩ khác.
|
|
|
|
7. Nhiễm khuẩn bệnh viện: Một số vi khuẩn trong bệnh viện kháng lại được cả những loại kháng sinh mạnh nhất. Theo thống kê, 75.000 người chết mỗi năm vì nhiễm khuẩn chéo tại bệnh viện. Trước khi khám bệnh, bạn có thể yêu cầu các bác sĩ và y tá rửa tay, ngay cả khi họ đeo găng tay.
|
|
|
|
8. Sử dụng thuốc quá liều: Các bệnh viện đôi khi cho bệnh nhân dùng quá liều thuốc quy định. Khi phải nằm viện, bạn nên yêu cầu một danh sách các loại thuốc và liều dùng hàng ngày, kiểm tra cẩn thận trước khi uống.
|
|
|
|
9. Bắt cóc trẻ em: Từ năm 1983, 132 trẻ sơ sinh bị bắt cóc tại các cơ sở chăm sóc y tế ở Mỹ. Mặc dù bệnh viện có các biện pháp an ninh để ngăn chặn vấn nạn bắt cóc, bạn vẫn phải đề phòng và nên biết rõ mặt những bác sĩ, y tá chăm sóc con bạn. Đặc biệt, nếu gặp người chăm sóc mới, cần hỏi rõ thẻ nhân viên của họ.
|
|
|
|
10. Truyền nhầm máu: Cứ 19.000 đơn vị máu lại có 1 đơn vị dùng không đúng cách. Bạn nên biết rõ nhóm máu của mình để kiểm tra túi máu có chính xác hay không trước khi truyền. |